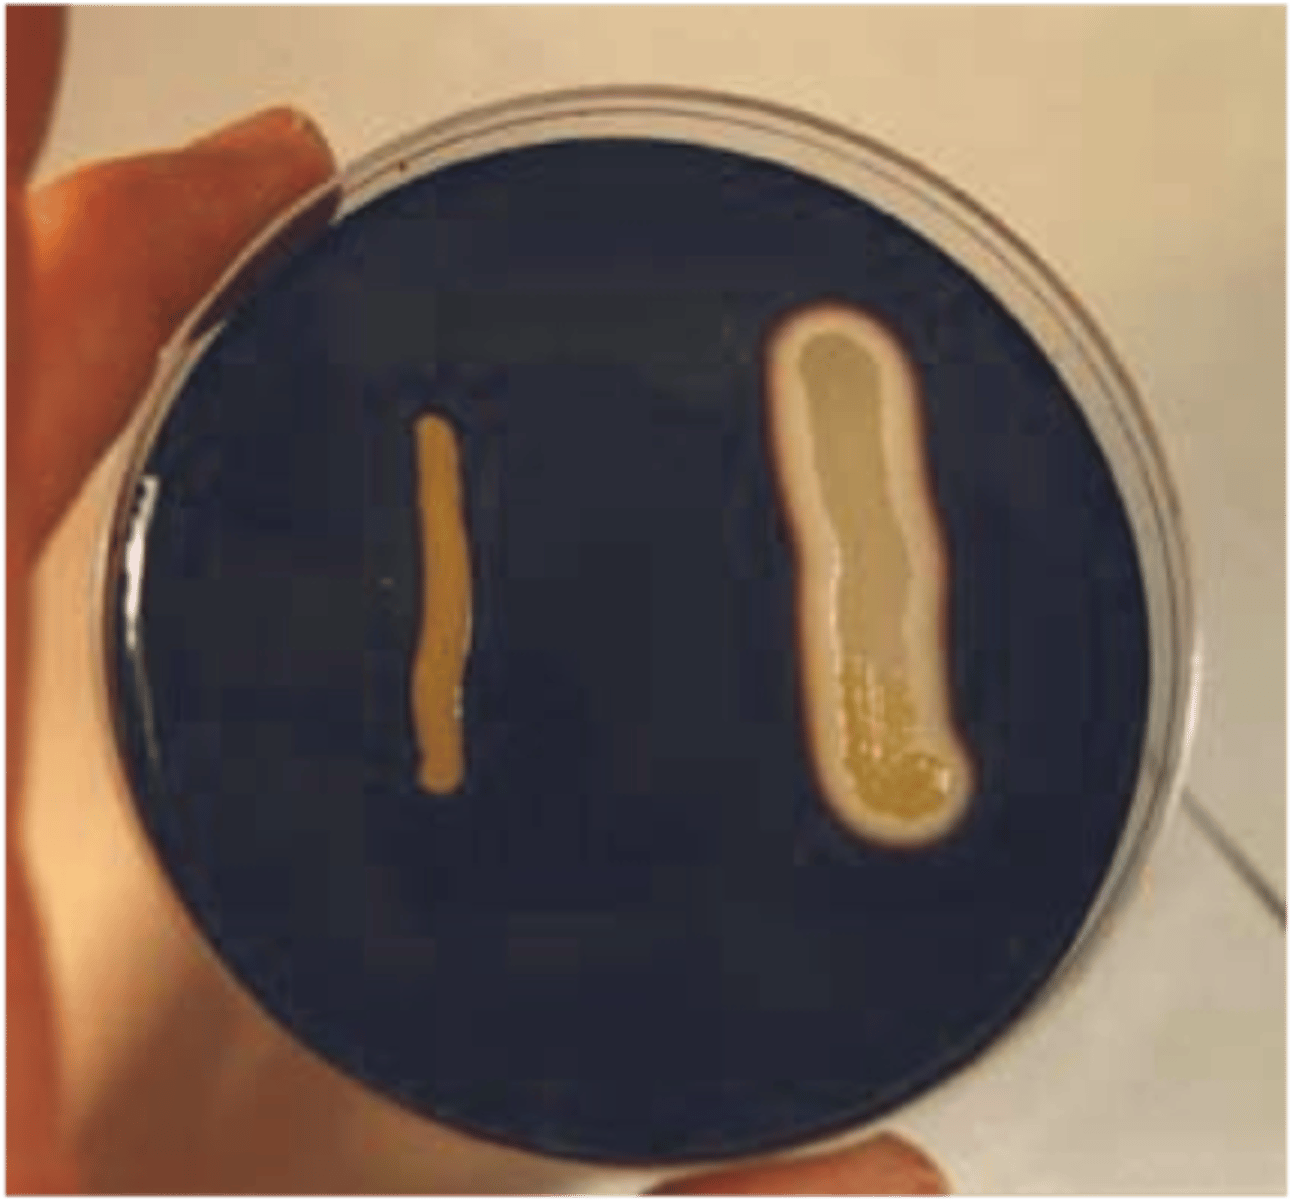
<p>1. starch</p><p>3. iodine</p><p>4. halo of clearing</p><p>5. no halo, all the starch is still present</p><p>6. differential</p>
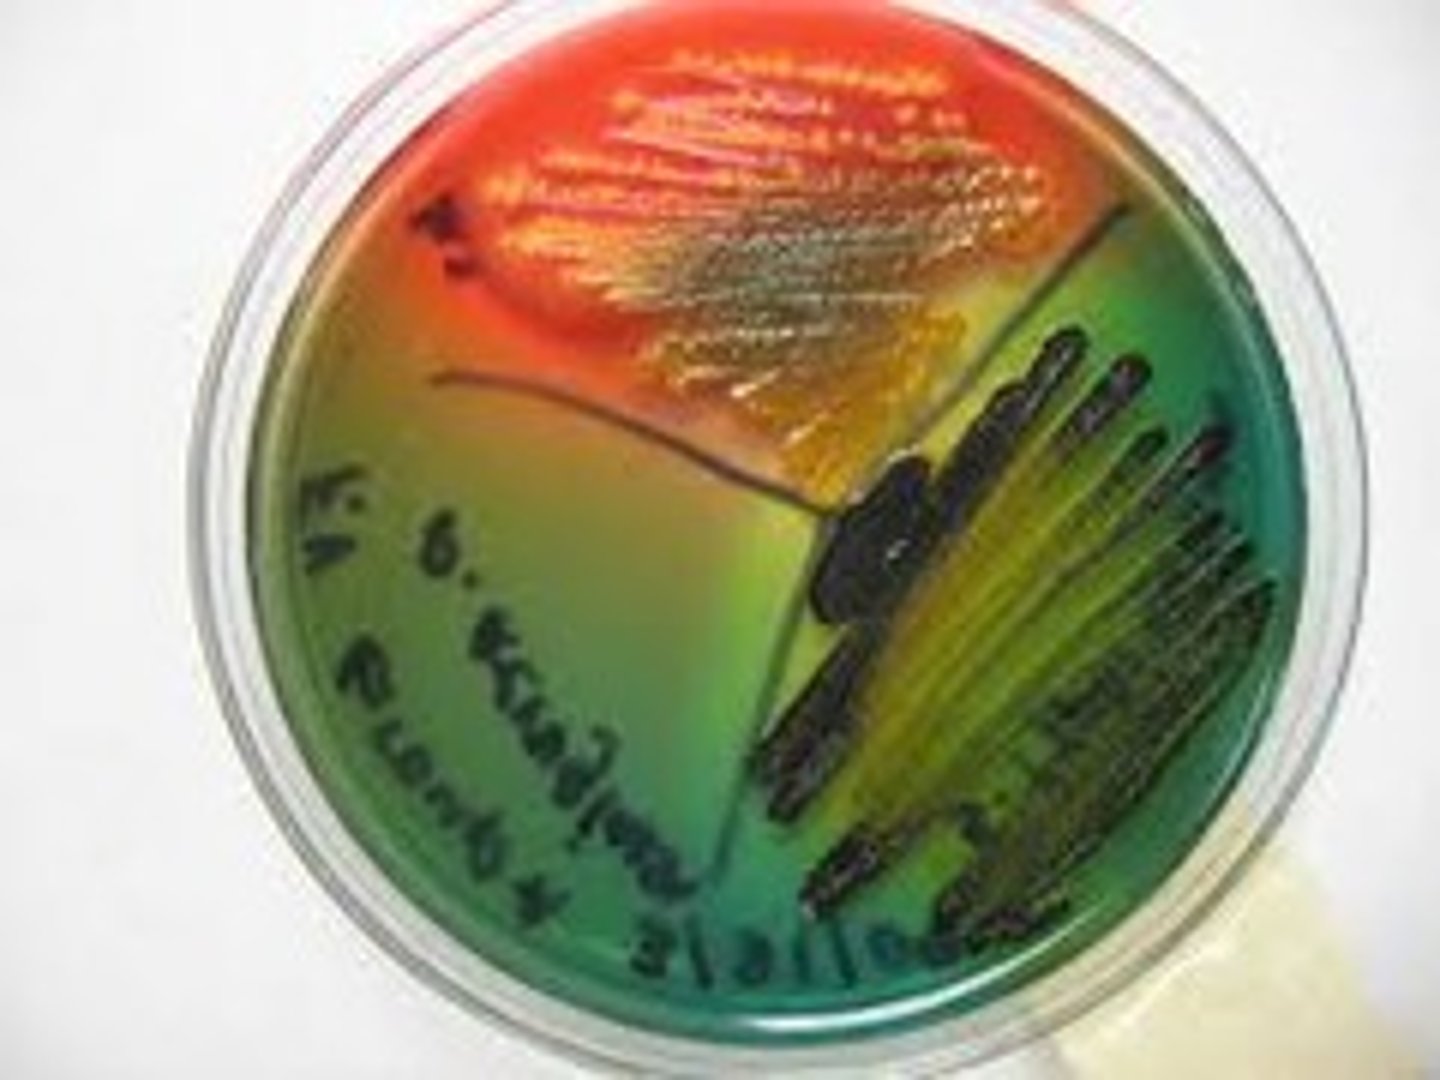
<p>HEA- Hektoen Enteric Agar</p><p>1a. lactose</p><p>1b. sodium thiosulfate (produces iron sulfide and forms black centers in the colonies if produced hydrogen sulfide)</p><p>2. bile salts</p><p>3. bromothymol blue</p><p>4. blue/ green colonies; non lactose fermenter</p><p>5. orange/ coral colonies; lactose fermenter</p><p>6. selective and differential media</p>
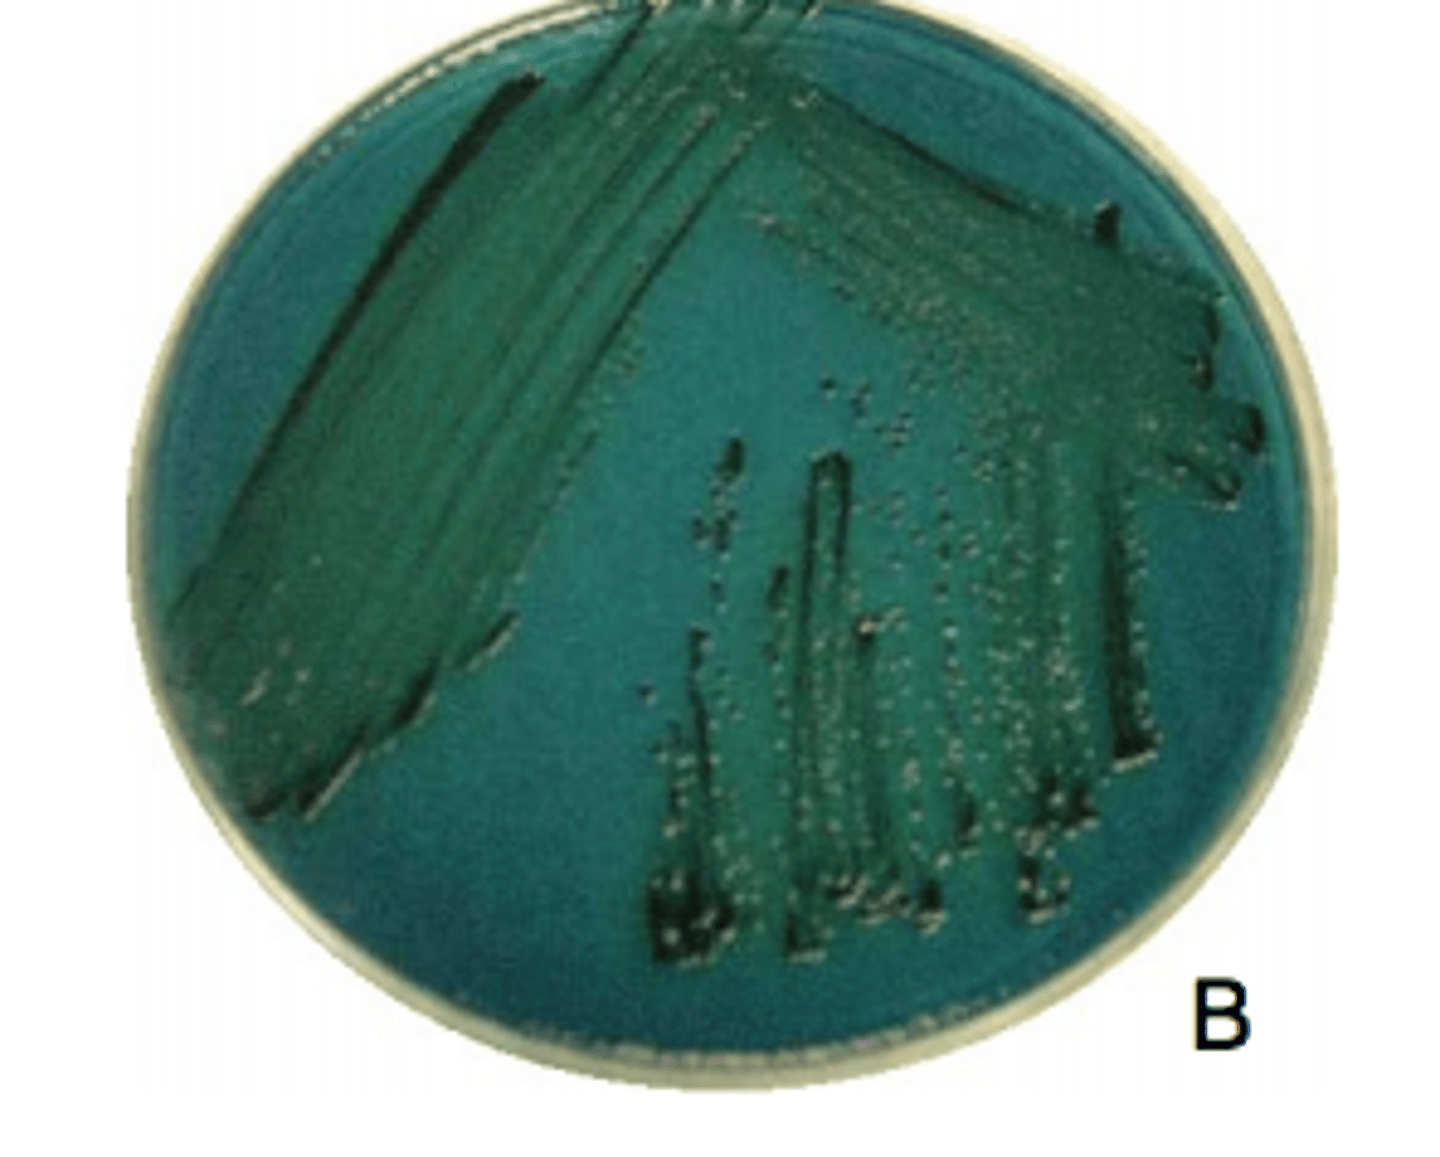
<p>salmonella</p>

1/104
Looks like no tags are added yet.
Name | Mastery | Learn | Test | Matching | Spaced | Call with Kai |
|---|
No analytics yet
Send a link to your students to track their progress
Using the chart provided in the lab manual, is the bacteria sensitive, resistant, or intermediate to the antibiotics based on the measurements taken?
Tetracycline: 0 mm
Gentamicin: 15 mm
Select one:
a. tetracycline: intermediate; gentamicin: sensitive
b. tetracycline: sensitive; gentamicin: intermediate
c. tetracycline: resistant; gentamicin: resistant
d. tetracycline: resistant; gentamicin: sensitive
d. tetracycline: resistant; gentamicin: sensitive
If the bacteria grows all the way up to the antibiotic disc this means the bacteria is _____________ to the antibiotic.
Select one:
a. Sensitive
b. Intermediate
c. Resistant
c. Resistant
To read the results of antibiotic sensitivity the ________________ is measured.
Select one:
a. zone of growth
b. area of bacteria
c. size of colony
d. zone of inhibition
d. zone of inhibition
The ______________ test is used to identify how much antibiotic effectively kills the bacteria but doesn't harm the patient.
Select one:
a. Minimum inhibitory concentration
b. Disc Diffusion
c. Plate count
d. Kirby Bauer
a. Minimum inhibitory concentration
What specialized media is used for the antibiotic sensitivity test?
Select one:
a. Mueller Hinton agar
b. Mannitol salt agar
c. Plate count agar
d. Tryptic soy agar
a. Mueller Hinton agar
When the bacteria completely engulfs the blood cell this is called ____________.
Select one:
a. beta hemolysis
b. gamma hemolysis
c. alpha hemolysis
a. beta hemolysis
In the MSA plate __________ is either used for fermentation or respiration by the bacteria.
Select one:
a. Mannitol
b. Glucose
c. Methyl red
d. Salt
a. Mannitol
____________ is the enzyme responsible for the break down of gelatin.
Select one:
a. Catalase
b. Gelatinase
c. Amylase
d. Oxidase
b. Gelatinase
_____________ gives the colony/media a green color when reading the results.
Select one:
a. Alpha hemolysis
b. Gamma hemolysis
c. Beta hemolysis
a. Alpha hemolysis
_________ is the indicator that needs to be added to the starch plates to read the results.
Select one:
a. HCl
b. Kovac's
c. Phenol red
d. Iodine
d. Iodine
What happens to the pH of the plate when the bacteria ferments the sugar in the MSA plate?
Select one:
a. goes down
b. goes up
c. stays the same
a. goes down
Because of the selective agent _____________, only Staph sp. grow on MSA.
Select one:
a. salt
b. blood
c. phenol red
d. mannitol
a. salt
Starch is a ____________ that is too large for the bacteria to utilize so it must first break it down.
Select one:
a. protein
b. amino acid
c. monosaccharide
d. polysaccharide
d. polysaccharide
What is the selective agent in HEA media?
Select one:
a. Crystal violet
b. Salt
c. Bile salts
d. Phenyl ethanol
c. Bile salts
What is the indicator in the EMB media that turns color during fermentation?
Select one:
a. Bromothymol blue
b. Crystal Violet
c. Phenol red
d. Eosin and Methylene Blue
d. Eosin and Methylene Blue
If you streak an organism on PEA and it grows this tells you that the organism is _______________.
Select one:
a. Gram positive
b. Non-fermentor
c. Fermentor
d. Gram negative
a. Gram positive
PEA is an example of ___________ media.
Select one:
a. Differential
b. Both selective and differential
c. Selective
c. Selective
What is the selective agent in PEA?
Select one:
a. Salt
b. Eosin Methylene Blue
c. Crystal Violet
d. Phenyl ethanol
d. Phenyl ethanol
What is the indicator in the HEA media?
Select one:
a. Bile salts
b. Methylene blue
c. Crystal violet
d. Bromothymol blue
d. Bromothymol blue
What is the substrate in EMB media?
Select one:
a. Glucose
b. Sucrose
c. Mannitol
d. Lactose
d. Lactose
The substrate in MAC media is _________ that the bacteria will either use for fermentation or respiration.
Select one:
a. Glucose
b. Sucrose
c. Lactose
d. Mannitol
c. Lactose
If respiration occurs what color will the carbohydrate test be?
Select one:
a. Red
b. Yellow
c. Blue
d. Green
a. Red
What color will the TSI slant be for a result of A/A?
Select one:
a. Yellow/Red
b. All red
c. Red/Yellow
d. All yellow
d. All yellow
What pH indicator is in the carbohydrate test?
Select one:
a. Bromothymol Blue
b. Methyl red
c. Kovacs
d. Phenol red
d. Phenol red
If H2S was produced by the organism what color will you see in the tube?
Select one:
a. Yellow
b. Black
c. Red
d. Purple
b. Black
The ____________ is placed in the carbohydrate test to catch any gas that could be produced during fermentation.
Select one:
a. Phenol tube
b. Durham Tube
c. Respiration tube
d. Carb tube
b. Durham Tube
What color is a negative result for the VP test?
Select one:
a. Straw
b. Rust
c. Blue
d. Green
a. Straw
What reagent is added to the indole test to read the results?
Select one:
a. Kovac's
b. Methyl Red
c. Alpha napthol
d. Bromothymol Blue
a. Kovac's
What indicator is added to the methyl red test to read the results?
Select one:
a. Glucose
b. Methyl Red
c. Kovacs
d. Bromothymol Blue
b. Methyl Red
What is the substrate in the citrate test?
Select one:
a. Acids
b. Carbonate
c. Citrate
d. Glucose
c. Citrate
What needs to be added to the VP tube before the indicator is added?
Select one:
a. Phenol Red
b. Iodine
c. KOH
d. Alcohol
c. KOH
If the organism doesn't test positive for the methyl red test what could be the potential product in the vogues proskauer test?
Select one:
a. Carbonate
b. Acids
c. Glucose
d. Acetoin
d. Acetoin
What is the substrate in the methyl red test?
Select one:
a. Citrate
b. Lactose
c. Tryptophan
d. Glucose
d. Glucose
What is the substrate in the indole test?
Select one:
a. Citrate
b. Glucose
c. Lactose
d. Tryptophan
d. Tryptophan
What is the indicator that is in the citrate tube?
Select one:
a. Methyl Red
b. Methylene blue
c. Phenol Red
d. Bromothymol blue
d. Bromothymol blue
when/why do we do a streak plate?
when we have a sample of bacteria and we want to get an insolated colony
what is the streak plate technique?
draw a "T" on the dish. using a loop, flame it and get your bacteria, then apply it to your first quadrant (biggest), flame the loop, then drag a few cells from the first to the second quadrant, flame the loop, then drag the last bit of cells into the third quadrant from the second. only a few cells should grow in the third quadrant and create isolated colonies.
antibiotic definition
against life
Kirby-Bauer method of antibiotic sensitivity
a broth culture is spread on an entire plate to create a "lawn" of growth, and discs with certain amounts of antibiotics are placed on the plates and allowed to diffuse in the media
how to read results of kirby-bauer method?
measure the diameter (whole thing from one side to the other) of zone of inhibition in millimeters, look at chart and find the antibiotic name and locate your measurement to determine if resistant, intermediate, or sensitive
how do antibiotics work?
they interfere with biochemical pathways
broad spectrum antiobiotics
inhibit growth of both gram positive and gram negative
narrow spectrum antibiotics
inhibit growth in a certain set of bacteria (either gram positive or gram negative, not both)
Antibiotics can be artificially made ________________________ and can be purified from other _____________________: ____________ (penicillin) or ________________ (streptomycin).
in a lab, microorganisms, fungi, bacteria
selective media
media that has a selective agent in it that only allows certain organisms to grow
differential media
media that has an indicator in it to show differences in bacterial metabolism to help identify an unknown organism
combination of selective and differential media
media that selects for growth of certain bacteria and then differentiates between those bacteria (pathogen vs. non-pathogen)
GEL test
1. substrate:
3. indicator:
4. positive result:
5. negative result:
6. media type:
1. gelatin
3. Hydrochloric acid (HCl)
4. halo of clearing
5. no halo of clearing; all the gelatin is still present
6. differential media

what are we looking for in a GEL test?
does the bacteria have the ability to eat/break down the gelatin
what is created if the bacteria can break the gelatin down in the GEL test?
gelatinase- the enzyme responsible for the hydrolysis of gelatin
STA (starch) test
1. substrate:
3. indicator:
4. positive result:
5. negative result:
6. media type:
1. starch
3. iodine
4. halo of clearing
5. no halo, all the starch is still present
6. differential
what are we looking for in the STA test?
can the bacteria break down starch
what is created if the bacteria can break the starch down in the STA test?
amylase- enzyme responsible for hydrolysis of starch
MSA test
1. substrate:
2. selective agent:
3. indicator:
4. positive result:
5. negative result:
6. media type:
MSA- Mannitol Salt Agar
1. mannitol
2. 7% NaCl (salt), selects for staph
3. phenol red
4. growth and yellow plate (staph aureus ONLY), growth and red plate (staph epidermis ONLY)
5. no growth and red plate
6. selective and differential media

what happens when the mannitol in MSA test is fermented?
acid is produced and turns the media yellow, staph aureus ONLY
what happens when the mannitol in MSA test is not fermented but is positive?
the mannitol was used for respiration, allowing for bacterial growth but leaving the plate red (staph epidermis)
SBA test
1. substrate:
4. alpha hemolysis:
5. beta hemolysis:
6. gamma hemolysis:
7. type of media:
SBA- Sheep's Blood Agar
1. blood
4. incomplete lysis- bacteria takes nutrients out but leaves the blood cells behind because it cant be consumed by the bacteria (green tint around the cells) (darker red in plate)
5. complete lysis- bacteria completely consumes blood cells (clearing around the bacteria colonies) (lighter red plate)
6. bacteria grows on the plate but does not use the blood cells at all
7. differential media

what are we looking for in the SBA test?
does the bacteria have the ability to eat blood cells
what is the SBA used to test for?
strep throat
PEA test
1. substrate:
2. selective agent:
4. positive result:
5. negative result:
6. media type:
PEA - Phenyl Ethanol Agar
1. phenyl ethanol (alcohol)
2. phenyl ethanol (alcohol)
4. growth
5. no growth
6. selective media

What does the PEA test select for?
gram positive organisms
what type of organism can't grow on PEA and why?
gram negative because alcohol disrupts the LPS layer of the cell wall
MAC test
1. substrate:
2. selective agent:
3. indicator:
4. positive result:
5. negative result:
6. media type:
MAC- MacConkey Agar
1. lactose; disaccharide made up of glucose and galactose
2. bile salts and crystal violet
3. neutral red
4. hot pink colonies (lactose fermenter)
5. colorless colonies (non lactose fermenter)
6. selective and differential media

What does the MAC test select for?
gram negative and enteric organisms (only these can grown)
why do we perform the MAC test?
does the bacteria ferment the lactose
What happens to the pH if fermentation occurs in the MAC test?
pH goes down, becomes acidic
What happens to the pH if respiration occurs in the MAC test?
pH goes up, becomes neutral or basic (like water)
EMB test
1. substrate:
2. selective agent:
3. indicator:
4. positive result:
5. negative result:
6. media type:
EMB- Eosin Methylene Blue Agar
1. lactose (disaccharide made up of glucose and galactose)
2. eosin/ methylene blue
3. eosin/ methylene blue
4. purple colonies; purple with green metallic sheen; lactose fermenter
5. colorless colonies; non lactose fermenter
6. selective and differential media

what bacteria on EMB creates a green metallic sheen?
e. coli ONLY
what does the EMB test select for?
gram negative and enteric organisms
HEA test
1a. substrate:
1b. secondary substrate:
2. selective agent:
3. indicator:
4. positive result:
5. negative result:
6. media type:
HEA- Hektoen Enteric Agar
1a. lactose
1b. sodium thiosulfate (produces iron sulfide and forms black centers in the colonies if produced hydrogen sulfide)
2. bile salts
3. bromothymol blue
4. blue/ green colonies; non lactose fermenter
5. orange/ coral colonies; lactose fermenter
6. selective and differential media
what does the HEA test select for?
gram negative and enteric organisms, but selects AGAINST E. coli (will not grow, only negative bacteria that doesnt grow)
what diseases are being tested for with the HEA test?
salmonella and shigella
Which disease produces black centers in the HEA test?
salmonella
what is in the tubes being tested for TSI and Carbohydrates?
TSI (triple sugar iron)
lactose (disaccharide)
glucose (monosaccharide)
sucrose (disaccharide)
mannitol (monosaccharide)
what does gas and H2S look like in a TSI tube?
gas would have cracks and H2S would have black

what are we looking for in carbohydrate testing?
does bacteria have the ability to ferment the sugar?
what color is the carbohydrate tube for fermentation and respiration?
yellow for fermentation, red for respiration
what is a durham tube?
a small glass tube placed upside down in the big culture tube to catch the gas produced as a biproduct of the bacteria
What sugars are in TSI and what are their concentrations?
lactose (1%), sucrose (1%), and glucose (0.1%)
Carbohydrate tube information
1. substrate(s):
2. indicator(s):
3. positive result:
4. negative result:
1. lactose, glucose, sucrose, mannitol
2. phenol red
3. yellow
4. red
how to read TSI tubes
slant/butt
TSI tube reading A and K meaning
A= acid (fermentation)
K= alkaline (respiration)
all yellow TSI tube (what does it mean and what is the reaction)
fermentation occured; reaction is A/A
red slant and yellow butt TSI tube (what does it mean and what is the reaction)
some fermentation occurred and some respiration occurred; glucose is the only sugar fermented (small amount); reaction is K/A
all red TSI tube (what does it mean and what is the reaction)
no fermentation occurred; K/K
how to inoculate TSI tubes
take the loop, flame it, get bacteria, push the loop all the way to the bottom of the tube and pull up then slide it over the top of the slant
how to inoculate carbohydrate tube
flame loop, get bacteria, dip in the liquid and swirl
what to ask when reading a TSI tube
slant/butt, H2S production?, gas production?
(ex: A/A, no H2S, gas produced)
what to ask when reading carbohydrate liquid tubes
fermentation? (whats the color), gas?
(ex: positive, gas produced)
what does IMVIC stand for?
Indole, Methyl Red, Voges-Proskauer, Citrate
What kind of bacteria is the IMVIC test performed on and why?
gram negative bacteria, to differentiate between E. coli and other intestinal bacteria
Indole test
1. substrate:
2. important products:
3. reagent:
4. positive:
5. negative:
1. tryptophan- amino acid that some bacteria can break down if they have the enzyme trytophanase
2. indole, pyruvate, and ammonia
3. Kovac's reagent-reacts with indole and produces a red ring
4. red ring
5. no ring

why do we perform the indole test?
to determine if the bacteria can break down tryptophan
Methyl red test
1. substrate:
2. type of fermentation:
3. reagent:
4. positive:
5. negative:
1. glucose-peptone (glucose)
2. mixed acid fermentation (glucose fermented into different forms of acid)
3. methyl red reagent- pH indicator
4. pH drop, turns red
5. pH increase, turns gold
what are we trying to determine when performing the methyl red test?
does the bacteria have the ability to ferment the glucose
what are we testing for in methyl red?
acidic products
Voges-Proskauer Test
1. substrate:
2. pathway:
3. reagent:
4. positive:
5. negative:
6. added product
1. glucose
2. butylene glycol pathway (looks for production of 2-3 butanediol that some bacteria performs)
3. alpha naphthol (reacts with the acetoin)
4. red
5. yellow
6. KOH
what are we testing for in VP test?
fermentation, basic products
why do we add KOH to the vogues-proskauer test?
to neutralizes any acid that may interfere with the product